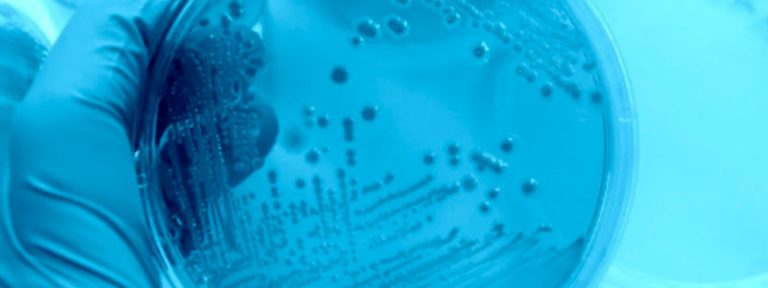

Catalogue
Votre métier
Selon votre secteur d’activité, trouvez le produit qui sera le plus adapté à vos besoins de nettoyage
Découvrir les secteurs d’activitésNotre engagement
éco-responsable
Solipro s’implique depuis plusieurs années pour réduire au quotidien l’impact de ses produits sur l’environnement et la santé des utilisateurs
En savoir plusSolipro, votre fournisseur en produits de nettoyage professionnel
Depuis plus de 50 ans, Solipro, division professionnelle de Bolton Home Care, catégorie de Bolton dédiée aux marques pour l’entretien de la maison, est un acteur reconnu en France. Nous sommes spécialisés dans la commercialisation de produits d’hygiène et de désinfection pour les professionnels.
Découvrez notre gamme
de produits d’hygiène
profesionnels écologiques
de produits d’hygiène
profesionnels écologiques
Nos produits de nettoyage écologiques sont écolabellisés par le centre de certification européen AFNOR ou écocertifiés par le centre de certification indépendant Ecocert.
Nos solutions de produits d’hygiène profesionnels
pour tous types d’applications
Solipro allie qualité, performance et écologie pour offrir des solutions efficaces et respectueuses de l’environnement
Solipro propose des solutions fiables et performantes, alliant qualité et respect de l’environnement. L’entreprise privilégie des pratiques écologiques pour répondre efficacement aux besoins de ses clients, tout en contribuant à la préservation de la planète.
Réglementation hygièneUn produit de nettoyage et d’entretien dédié à chaque besoin
Dans le monde exigeant du nettoyage professionnel, la précision et l’efficacité sont des impératifs. Chaque environnement, qu'il s'agisse d'un restaurant, d’un hôpital, d'une école, d'un bureau ou d'une usine, possède des besoins spécifiques en matière d’hygiène et de propreté. C’est pourquoi il est crucial de disposer de produits d’entretien adaptés à chaque protocole de nettoyage.
Des solutions adaptées à chaque protocole de nettoyage
Le professionnalisme et la proximité de notre équipe commerciale nous permettent de comprendre vos besoins et de vous proposer des solutions adaptées à toutes les exigences en matière de nettoyage et d’hygiène.
En savoir plusLe catalogue Solipro
Découvrez une gamme complète de produits nettoyants pour une désinfection professionnelle et une hygiène optimale : décapants, dégraissants, nettoyants, désinfectants, détachants, détartrants, désodorisants...
Les dernières actualités

Solipro participe au Snack Show 2026 !
Venez rencontrer l’équipe Solipro et découvrir nos dernières nouveautés en solutions professionnelles pour le snacking. Produits faciles à utiliser,…

Le QR code sur nos étiquettes
Dans le secteur de l’hygiène professionnelle, l’accès rapide à une information fiable, à jour et…
Certibiocide Désinfectant
Au 1er janvier 2026, la mise en œuvre du Certibiocide Désinfectant devient effective !



























